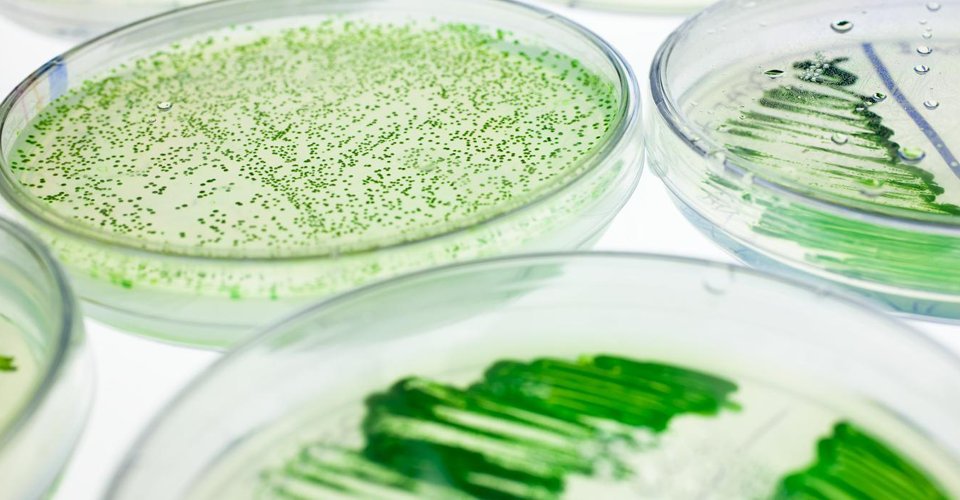
‘It’s inevitable that #algae will become a larger part of the food supply in the future’
bit.ly/2xfTU2Y 
#FutureOfFood #NovelFoods

The Algae Factory™
@thealgaefactory
The official Twitter account of The Algae Factory™. We develop algae based snacks for happy and healthy consumers. BITE4BITE™
ID: 2797832521
http://www.thealgaefactory.com 08-09-2014 12:10:48
1,1K Tweet
1,1K Followers
2,2K Following



Proud to collaborate with Mieux Nourrir et Grandir to #fight #malnutrition with our #spirulina #snacks! #bite4bite #health #superfood #chocolate #protein x.com/AntennaF/statu…


These 13 Insta-Worthy #Spirulina Photos Are Basically What #Dreams Are Made Of elitedaily.com/envision/food/… via Elite Daily #food #bowl #smoothie






#Spirulina finds success in #Dutch start-up's #algae #chocolate! foodnavigator.com/Article/2018/0… StartLifeNL StartHub Wageningen FoodNavigator.com FoodNavigator-USA Diane de Jouvencel 🌿 Founded in Holland F&A Next @linzelive

From FoodNavigator.com: Dutch startup (& FB! alum) The Algae Factory™ is pushing the food-pairing boundaries with its #algae #chocolate that contains sustainably sourced #spirulina: bit.ly/2myz8s6 #foodtech


#Alga #spirulina, #canapa e #cioccolato: lo #snack è salutare (e sostenibile) - wisesociety.it/alimentazione/… via Wise Society puntoITALY @bio

Bigger size, bigger #pleasure! #chocolate #spirulina StartLifeNL @linzelive Amsterdam Made @MarqtAmsterdam FoodNavigator.com Amsterdam Foodie Cam Food Inspiration Founded in Holland F&A Next shop.thealgaefactory.com/collections/al…

Why you should be cooking with #algae, the latest #superfood telegraph.co.uk/food-and-drink… via Telegraph Food


Grazie FreshPlaza Italia per l'articolo! Curiosi di provare i nostri prodotti? #alghe #spirulina #snack freshplaza.it/article/97967/…


Thank you AGF.nl for the article! StartLifeNL @linzelive Founded in Holland @hfoodvalley F&A Next agf.nl/artikel/172264…